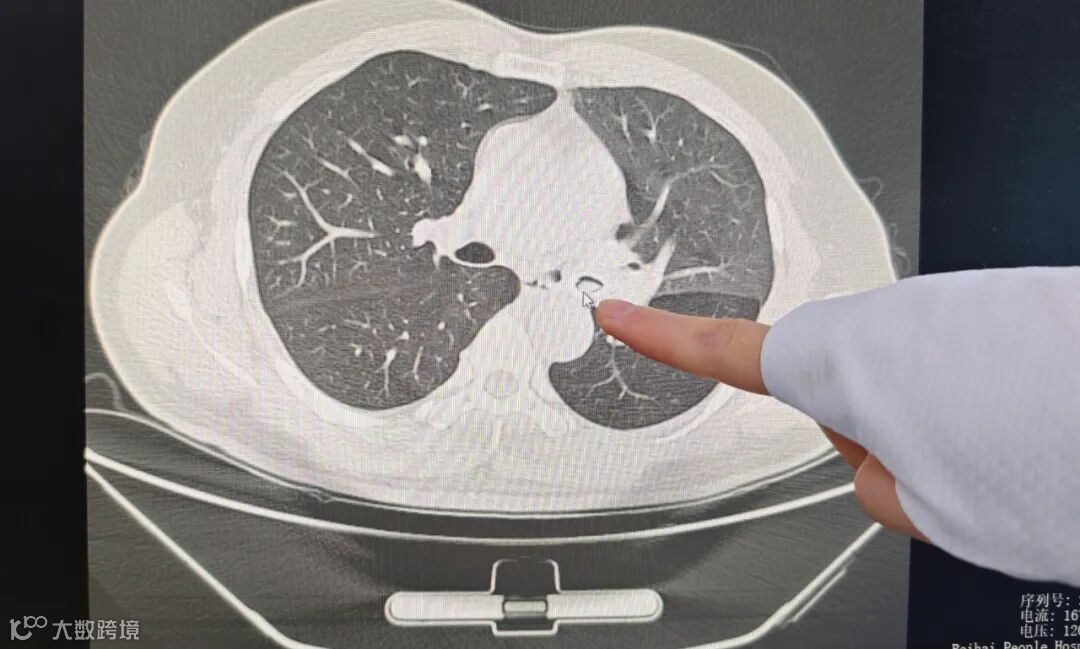

北海61岁男子误呛话梅
医生十分钟成功取出
6月4日19时,61岁的陈叔(化名)正躺在沙发上边看手机边吃话梅。突然,一颗话梅滑入气管!家属立即采用海姆立克法急救,但未能奏效,急得直掉眼泪!20时,出现气喘、胸痛等症状的陈叔被紧急送往北海市人民医院。
6月5日10点40分,在局部麻醉下,呼吸与危重症医学科副主任刘春妮、副护士长林晓燕等手术团队准备了4把包括网篮、异物钳、抓手钳等特制钳子取气管异物。

经过精准夹持,刘春妮用抓手钳用时不到10分钟便成功取出异物,确定是一颗完整的话梅。

术后,男子便想办理出院。值班医生耐心劝导打算当天出院的患者:“虽然异物取出,但气道黏膜受刺激,仍需留院观察消炎,避免感染风险。”

医生提醒
针对气管异物意外频发的情况,刘春妮特别提醒:“进食时应避免大笑、打闹或讲话,老人和儿童尤其要注意。一旦发生异物呛入,需立刻采用海姆立克法急救,并及时就医。若急救后症状未缓解,切勿抱有侥幸心理,黄金抢救时间往往只有几分钟。”
- END -
➤内容来源:北海市人民医院 | 版权归原作者所有
➤图文编辑:北海阿叔-豆腐|转载请注明








